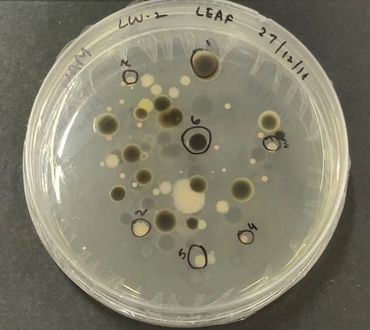

PhD positions are open. Contact us to join our research team!
PhD positions are open. Contact us to join our research team!




.jpg/:/cr=t:0%25,l:0%25,w:100%25,h:100%25/rs=w:370,cg:true)

Carbon dioxide enrichment facility

.jpeg/:/rs=w:370,cg:true,m)
.jpeg/:/cr=t:0%25,l:0%25,w:100%25,h:100%25/rs=w:370,cg:true)

We use cookies to analyze website traffic and optimize your website experience. By accepting our use of cookies, your data will be aggregated with all other user data.